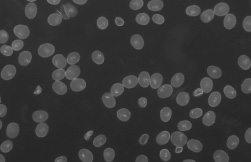
pollen grain image with fluorescence microscop pollen grain image with fluorescence microscope

Using a Microscope to Inspect Grains: A Case Study with Rye Crops
Oct 24th 2023
Grains are a staple food source for the world’s population. For example, an estimated 784 million metric tons of wheat will be produced worldwide in 2022/2023. Therefore, developing new, improved production methods are critical to ensuring an adequate food supply. Microscopes can be used to inspect plant characteristics that are important to optimizing crop yields.
Case Study Using Eternal Rye:
Dr. Dreissig and his team of scientists at the Martin Luther University in Halle-Wittenberg, Germany are using several types of microscopes to analyze the effects of different types of fertilization (using industrial or farmyard manure) on rye plants. For their research, examining the pollen morphology and measuring pollen size is of critical importance. These parameters help the team to determine the impact of different fertilization methods on rye production. Each flower of the rye plant contains six pollen anthers.

This image shows an image of the rye flower using a stereo microscope. The pollen-containing anthers are visible. Image © Martin-Luther-Universitiy Halle-Wittenberg, Germany.

The pollen anthers are removed from the rye flower under a stereo microscope. Image © Martin-Luther-Universitiy Halle-Wittenberg, Germany.
Then, pollen grains, which are contained within pollen sac chambers in the anthers, can be removed, counted, and examined under the microscope. The pollen grain samples were stained in order to visualize the grains using a fluorescence microscope.
Pollen grains normally contain three nuclei. Image © Martin-Luther-Universitiy Halle-Wittenberg, Germany.
Dr. Dreissig and his team hope to understand what genes influence rye pollen size so that in the future, pollen size can be optimized by manipulating the genome of the rye plants to produce the highest crop yields. Then, the hope is that the knowledge of these genomic changes can be used to optimize production of other grain-producing crops, such as wheat.
This case study shows how different types of microscopes can help identify plant characteristics that are important for optimal crop production. Contact Microscope World to learn more about what kinds of microscope systems are appropriate for your plant research applications.
References:
Dr. Steven Dreissig, Natalie Koch (Martin-Luther-University Halle-Wittenberg, Germany
Anke Koenen, Carl Zeiss Microscopy GmbH, Jena, Germany



